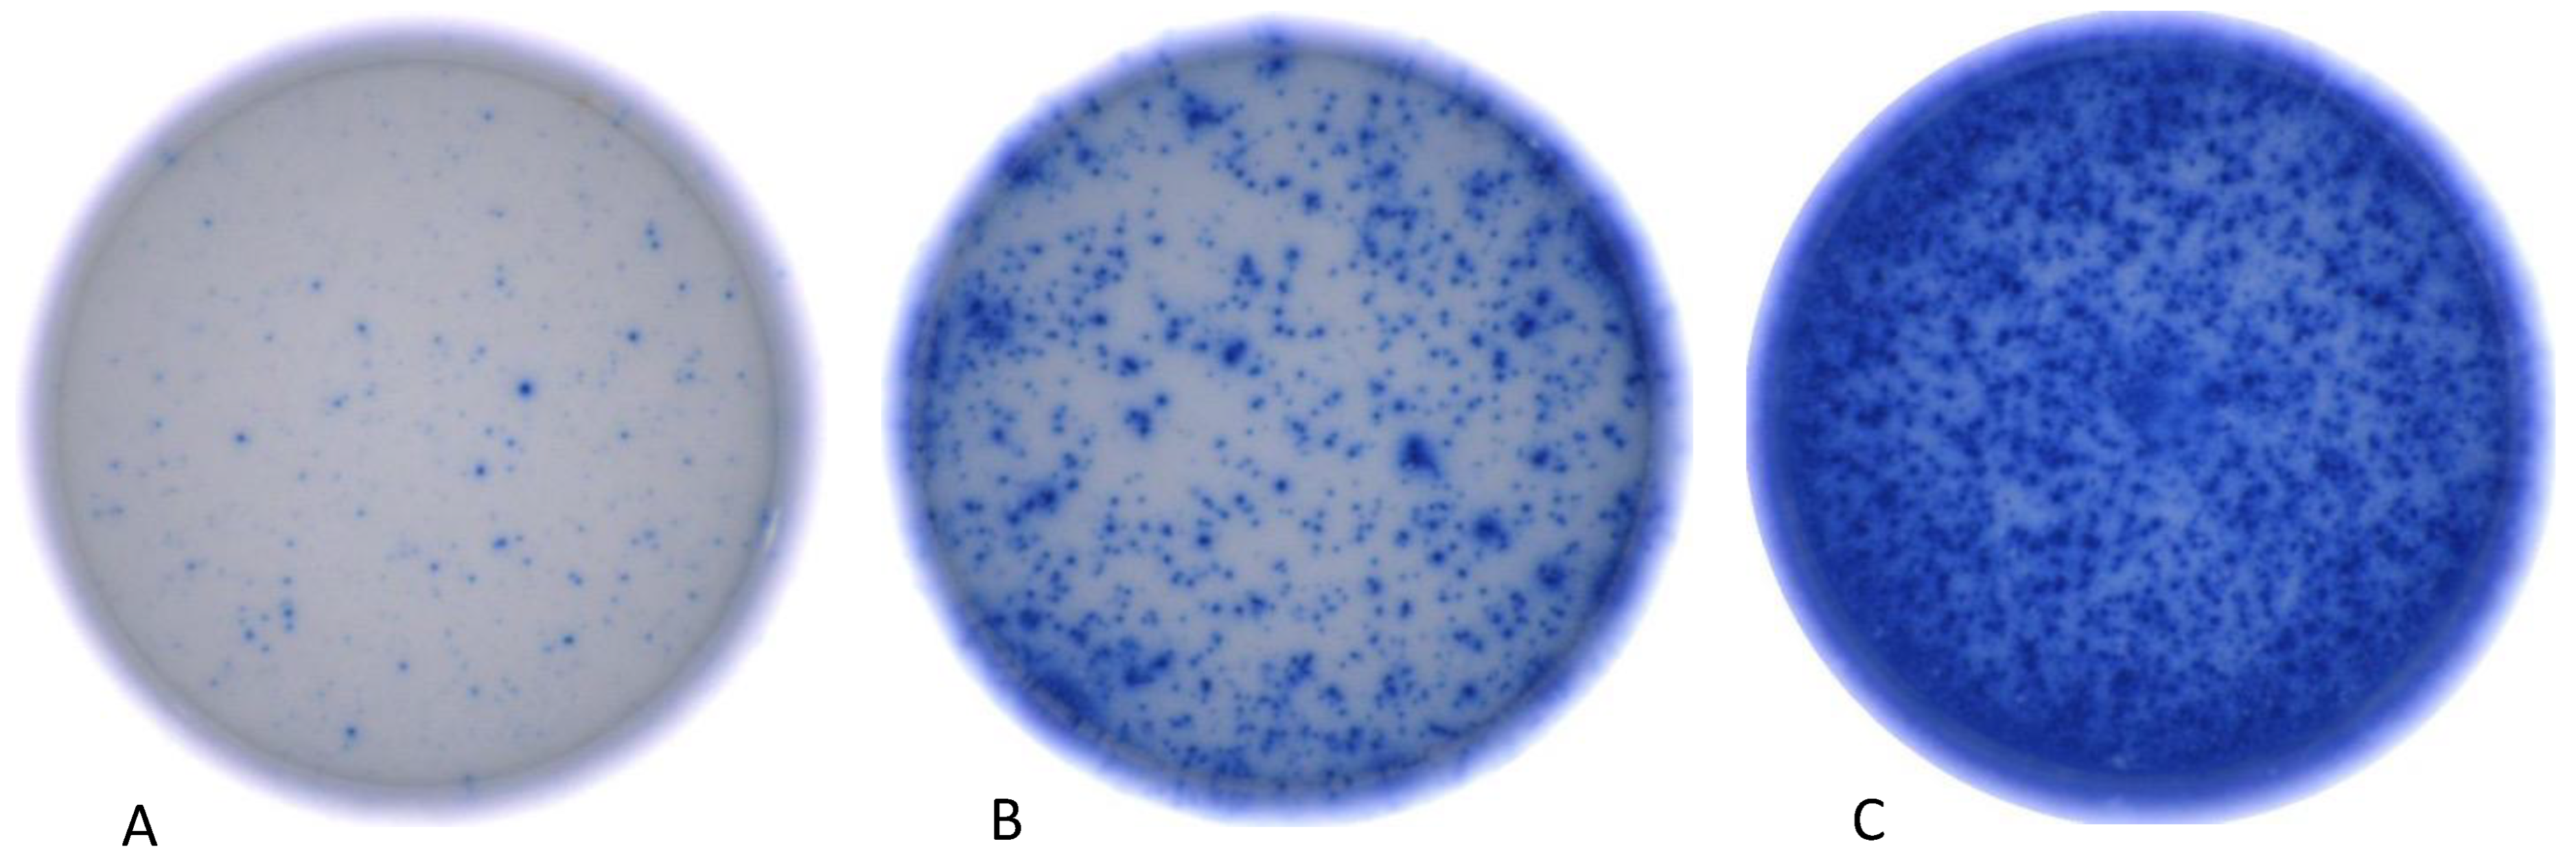
Cells 13 00741 g002

Immunomonitoring via ELISPOT Assay Reveals Attenuated T-Cell Immunity to CMV in Immunocompromised Liver-Transplant Patients
Abstract
:1. Introduction
2. Materials and Methods
2.1. Patient Cohort and Peripheral Blood Mononuclear Cell (PBMC) Sampling
2.2. Thawing and Preparation of Cells
2.3. Antigens
2.4. Human Interferon-y Immunospot Assay
2.5. Statistical Analysis of Immunospot Assay
3. Results
3.1. Immunosuppressive Therapy Reduces Frequency of CMV Reactive T-Cells
3.2. Immunosuppressive Therapy Reduces IFN-γ Release of Antiviral T-Cells
3.3. Immunosuppressive Therapy Reduces the Total Number of Detected Experimental Antigen Approaches
3.4. Time Interval after Transplantation Correlates with Reduced IFN-γ Release of Antiviral T-Cells
3.5. Application of Prednisolone and Increasing Age Reduce CMV-Specific T-Cell Response
3.6. Appearance of CMV Reactivation during the Subsequent Clinical Course
4. Discussion
5. Conclusions
Author Contributions
Funding
Institutional Review Board Statement
Informed Consent Statement
Data Availability Statement
Conflicts of Interest
References
- Engelmann, C.; Sterneck, M.; Weiss, K.H.; Templin, S.; Zopf, S.; Denk, G.; Eurich, D.; Pratschke, J.; Weiss, J.; Braun, F.; et al. Prevention and Management of CMV Infections after Liver Transplantation: Current Practice in German Transplant Centers. J. Clin. Med. 2020, 9, 2352. [Google Scholar] [CrossRef]
- Cannon, M.J.; Schmid, D.S.; Hyde, T.B. Review of cytomegalovirus seroprevalence and demographic characteristics associated with infection. Rev. Med. Virol. 2010, 20, 202–213. [Google Scholar] [CrossRef]
- Jothimani, D.; Venugopal, R.; Vij, M.; Rela, M. Post liver transplant recurrent and de novo viral infections. Best Pract. Res. Clin. Gastroenterol. 2020, 46, 101689. [Google Scholar] [CrossRef]
- Herman, D.; Han, H. Cytomegalovirus in liver transplant recipients. Curr. Opin. Organ Transplant. 2017, 22, 345–350. [Google Scholar] [CrossRef]
- Lautenschlager, I. CMV infection, diagnosis and antiviral strategies after liver transplantation. Transplant. Int. 2009, 22, 1031–1040. [Google Scholar] [CrossRef]
- Kotton, C.N. CMV: Prevention, Diagnosis and Therapy. Am. J. Transplant. 2013, 13 (Suppl. S3), 24–40. [Google Scholar] [CrossRef]
- Razonable, R.R. Cytomegalovirus infection after liver transplantation: Current concepts and challenges. World, J. Gastroenterol. 2008, 14, 4849–4860. [Google Scholar] [CrossRef]
- Bosch, W.; Heckman, M.G.; Pungpapong, S.; Diehl, N.N.; Shalev, J.A.; Hellinger, W.C. Association of cytomegalovirus infection and disease with recurrent hepatitis C after liver transplantation. Transplantation 2012, 93, 723–728. [Google Scholar] [CrossRef]
- Pastacaldi, S.; Teixeira, R.; Montalto, P.; Rolles, K.; Burroughs, A.K. Hepatic artery thrombosis after orthotopic liver transplantation: A review of nonsurgical causes. Liver Transplant. 2001, 7, 75–81. [Google Scholar] [CrossRef] [PubMed]
- Razonable, R.R.; Paya, C.V. Infections and allograft rejection—Intertwined complications of organ transplantation. Swiss Med. Wkly. 2005, 135, 571–573. [Google Scholar] [CrossRef]
- Rashidi-Alavijeh, J.; Crämer, J.C.; Sauter, H.L.; Willuweit, K.; Straub, K.; Wedemeyer, H.; Herzer, K. Primary sclerosing cholangitis as an independent risk factor for cytomegalovirus infection after liver transplant. Transplant. Infect. Dis. 2021, 23, e13553. [Google Scholar] [CrossRef] [PubMed]
- Gliga, S.; Fiedler, M.; Dornieden, T.; Achterfeld, A.; Paul, A.; Horn, P.A.; Herzer, K.; Lindemann, M. Comparison of Three Cellular Assays to Predict the Course of CMV Infection in Liver Transplant Recipients. Vaccines 2021, 9, 88. [Google Scholar] [CrossRef] [PubMed]
- Shin, K.-H.; Lee, H.-J.; Chang, C.L.; Kim, E.J.; Lim, S.; Lee, S.J.; Ryu, J.H.; Yang, K.; Choi, B.H.; Lee, T.B.; et al. CMV specific T cell immunity predicts early viremia after liver transplantation. Transpl. Immunol. 2018, 51, 62–65. [Google Scholar] [CrossRef]
- Nowacki, T.M.; Bettenworth, D.; Ross, M.; Heidemann, J.; Lehmann, P.V.; Lügering, A. Cytomegalovirus (CMV)-Specific Perforin and Granzyme B ELISPOT Assays Detect Reactivation of CMV Infection in Inflammatory Bowel Disease. Cells 2012, 1, 35–50. [Google Scholar] [CrossRef] [PubMed]
- Almeida, C.-A.M.; Roberts, S.G.; Laird, R.; McKinnon, E.; Ahmed, I.; Pfafferott, K.; Turley, J.; Keane, N.M.; Lucas, A.; Rushton, B.; et al. Automation of the ELISpot assay for high-throughput detection of antigen-specific T-cell responses. J. Immunol. Methods 2009, 344, 1–5. [Google Scholar] [CrossRef] [PubMed]
- Kamperschroer, C.; O’Donnell, L.M.; Schneider, P.A.; Li, D.; Roy, M.; Coskran, T.M.; Kawabata, T.T. Measuring T-cell responses against LCV and CMV in cynomolgus macaques using ELISPOT: Potential application to non-clinical testing of immunomodulatory therapeutics. J. Immunotoxicol. 2014, 11, 35–43. [Google Scholar] [CrossRef] [PubMed]
- Terlutter, F.; Caspell, R.; Nowacki, T.M.; Lehmann, A.; Li, R.; Zhang, T.; Przybyla, A.; Kuerten, S.; Lehmann, P.V. Direct Detection of T- and B-Memory Lymphocytes by ImmunoSpot® Assays Reveals CMV Exposure that Serum Antibodies Fail to Identify. Cells 2018, 7, 45. [Google Scholar] [CrossRef]
- Kreher, C.R.; Dittrich, M.T.; Guerkov, R.; Boehm, B.O.; Tary-Lehmann, M. CD4+ and CD8+ cells in cryopreserved human PBMC maintain full functionality in cytokine ELISPOT assays. J. Immunol. Methods 2003, 278, 79–93. [Google Scholar] [CrossRef] [PubMed]
- Ramachandran, H.; Laux, J.; Moldovan, I.; Caspell, R.; Lehmann, P.V.; Subbramanian, R.A. Optimal Thawing of Cryopreserved Peripheral Blood Mononuclear Cells for Use in High-Throughput Human Immune Monitoring Studies. Cells 2012, 1, 313–324. [Google Scholar] [CrossRef]
- Wills, M.R.; Carmichael, A.J.; Mynard, K.; Jin, X.; Weekes, M.P.; Plachter, B.; Sissons, J.G. The human cytotoxic T-lymphocyte (CTL) response to cytomegalovirus is dominated by structural protein pp65: Frequency, specificity, and T-cell receptor usage of pp65-specific CTL. J. Virol. 1996, 70, 7569–7579. [Google Scholar] [CrossRef]
- Currier, J.R.; Kuta, E.G.; Turk, E.; Earhart, L.B.; Loomis-Price, L.; Janetzki, S.; Ferrari, G.; Birx, D.L.; Cox, J.H. A panel of MHC class I restricted viral peptides for use as a quality control for vaccine trial ELISPOT assays. J. Immunol. Methods 2002, 260, 157–172. [Google Scholar] [CrossRef]
- McLaughlin-Taylor, E.; Pande, H.; Forman, S.J.; Tanamachi, B.; Li, C.R.; Zaia, J.A.; Greenberg, P.D.; Riddell, S.R. Identification of the major late human cytomegalovirus matrix protein pp65 as a target antigen for CD8+ virus-specific cytotoxic T lymphocytes. J. Med. Virol. 1994, 43, 103–110. [Google Scholar] [CrossRef]
- Kondo, E.; Akatsuka, Y.; Kuzushima, K.; Tsujimura, K.; Asakura, S.; Tajima, K.; Kagami, Y.; Kodera, Y.; Tanimoto, M.; Morishima, Y.; et al. Identification of novel CTL epitopes of CMV-pp65 presented by a variety of HLA alleles. Blood 2004, 103, 630–638. [Google Scholar] [CrossRef]
- Barabas, S.; Spindler, T.; Kiener, R.; Tonar, C.; Lugner, T.; Batzilla, J.; Bendfeldt, H.; Rascle, A.; Asbach, B.; Wagner, R.; et al. An optimized IFN-γ ELISpot assay for the sensitive and standardized monitoring of CMV protein-reactive effector cells of cell-mediated immunity. BMC Immunol. 2017, 18, 14. [Google Scholar] [CrossRef]
- Immunospot Resources. ELISPOT Protocol. Available online: https://immunospot.com/human-ifn-gamma-single-color-elispot.html (accessed on 27 April 2023).
- Zhang, W.; Caspell, R.; Karulin, A.Y.; Ahmad, M.; Haicheur, N.; Abdelsalam, A.; Johannesen, K.; Vignard, V.; Dudzik, P.; Georgakopoulou, K.; et al. ELISPOT assays provide reproducible results among different laboratories for T-cell immune monitoring—Even in hands of ELISPOT-inexperienced investigators. J. Immunotoxicol. 2009, 6, 227–234. [Google Scholar] [CrossRef] [PubMed]
- Doherty, P.C. The numbers game for virus-specific CD8+ T cells. Science 1998, 280, 227. [Google Scholar] [CrossRef] [PubMed]
- Schlingmann, T.R.; Shive, C.L.; Targoni, O.S.; Tary-Lehmann, M.; Lehmann, P.V. Increased per cell IFN-gamma productivity indicates recent in vivo activation of T cells. Cell Immunol. 2009, 258, 131–137. [Google Scholar] [CrossRef] [PubMed]
- DGVS DGAV. S2k-Leitlinie Lebertransplantation der Deutschen Gesellschaft für Gastroenterologie, Verdauungs- und Stoffwech-selkrankheiten (DGVS) und der Deutschen Gesellschaft für Allgemein- und Viszeralchirurgie (DGAV). AWMF registre number: 021–029. Available online: https://register.awmf.org/de/leitlinien/detail/021-029 (accessed on 27 April 2023).
- Wiesner, R.H.; Demetris, A.J.; Belle, S.H.; Seaberg, E.C.; Lake, J.R.; Zetterman, R.K.; Everhart, J.; Detre, K.M. Acute hepatic allograft rejection: Incidence, risk factors, and impact on outcome. Hepatology 1998, 28, 638–645. [Google Scholar] [CrossRef]
- Ziolkowski, J.; Paczek, L.; Niewczas, M.; Senatorski, G.; Oldakowska-Jedynak, U.; Wyzgal, J.; Foroncewicz, B.; Mucha, K.; Zegarska, J.; Nyckowski, P.; et al. Acute liver transplant rejection: Incidence and the role of high-doses steroids. Transplant. Proc. 2003, 35, 2289–2291. [Google Scholar] [CrossRef]
- Everson, G.T.; Trotter, J.F.; Kugelmas, M.; Forman, L. Immunosuppression in liver transplantation. Minerva Chir. 2003, 58, 725–740. [Google Scholar]
- Adams, D.H.; Sanchez-Fueyo, A.; Samuel, D. From immunosuppression to tolerance. J. Hepatol. 2015, 62, S170–S185. [Google Scholar] [CrossRef]
- Gu, J.; Wu, X.; Lu, L.; Zhang, S.; Bai, J.; Wang, J.; Li, J.; Ding, Y. Role of steroid minimization in the tacrolimus-based immunosuppressive regimen for liver transplant recipients: A systematic review and meta-analysis of prospective randomized controlled trials. Hepatol. Int. 2014, 8, 198–215. [Google Scholar] [CrossRef]
- Parlakpinar, H.; Gunata, M. Transplantation and immunosuppression: A review of novel transplant-related immunosuppressant drugs. Immunopharmacol. Immunotoxicol. 2021, 43, 651–665. [Google Scholar] [CrossRef]
- Pedersen, M.; Seetharam, A. Infections after orthotopic liver transplantation. J. Clin. Exp. Hepatol. 2014, 4, 347–360. [Google Scholar] [CrossRef]
- Li, M.; Yao, D.; Zeng, X.; Kasakovski, D.; Zhang, Y.; Chen, S.; Zha, X.; Li, Y.; Xu, L. Age related human T cell subset evolution and senescence. Immun. Ageing 2019, 16, 24. [Google Scholar] [CrossRef]
- Briceño, O.; Lissina, A.; Wanke, K.; Afonso, G.; von Braun, A.; Ragon, K.; Miquel, T.; Gostick, E.; Papagno, L.; Stiasny, K.; et al. Reduced naïve CD8(+) T-cell priming efficacy in elderly adults. Aging Cell 2016, 15, 14–21. [Google Scholar] [CrossRef]
- Olsson, J.; Wikby, A.; Johansson, B.; Löfgren, S.; Nilsson, B.O.; Ferguson, F.G. Age-related change in peripheral blood T-lymphocyte subpopulations and cytomegalovirus infection in the very old: The Swedish longitudinal OCTO immune study. Mech. Ageing Dev. 2000, 121, 187–201. [Google Scholar] [CrossRef]
- Khan, N.; Shariff, N.; Cobbold, M.; Bruton, R.; Ainsworth, J.A.; Sinclair, A.J.; Nayak, L.; Moss, P.A.H. Cytomegalovirus seropositivity drives the CD8 T cell repertoire toward greater clonality in healthy elderly individuals. J. Immunol. 2002, 169, 1984–1992. [Google Scholar] [CrossRef]
- Schiller, A.; Zhang, T.; Li, R.; Duechting, A.; Sundararaman, S.; Przybyla, A.; Kuerten, S.; Lehmann, P.V. A Positive Control for Detection of Functional CD4 T Cells in PBMC: The CPI Pool. Cells 2017, 6, 47. [Google Scholar] [CrossRef] [PubMed]
- Banas, B.; Böger, C.A.; Lückhoff, G.; Krüger, B.; Barabas, S.; Batzilla, J.; Schemmerer, M.; Köstler, J.; Bendfeldt, H.; Rascle, A.; et al. Validation of T-Track® CMV to assess the functionality of cytomegalovirus-reactive cell-mediated immunity in hemodialysis patients. BMC Immunol. 2017, 18, 15. [Google Scholar] [CrossRef] [PubMed]

| One Immunosuppressant (n = 16) | Two Immunosuppressants (n = 27) | Three Immunosuppressants (n = 9) | p-Value | ||
|---|---|---|---|---|---|
| Patient characteristics | Age, years median (IQR) | 70 (55.5–73.5) | 54 (43–62) | 51 (36.5–65) | 0.051 |
| Gender, male (%) | 6 (37.5) | 14 (51.9) | 7 (77.8) | 0.18 | |
| Months after Transplantation, median (IQR) | 91 (57–157) | 53 (24–136) | 9 (3.5–40) | 0.001 | |
| Pre-existing conditions | Diabetes mellitus (%) | 5 (31.3) | 10 (37) | 1 (11.) | 0.35 |
| Kidney insufficiency (%) | 14 (87.5) | 19 (70.4) | 3 (33.3) | 0.017 | |
| Inflammatory disease (%) | 5 (31.3) | 5 (18.5) | 1 (11.1) | 0.44 | |
| Laboratory | Creatinine, mg/dL, median (IQR) | 1.4 (1.21–1.83) | 1.18 (0.85–1.43) | 1.03 (0.91–1.24) | 0.036 |
| Leucocytes, Tsd/µL, median (IQR) | 5.1 (3.67–7.3) | 5.5 (4.12–7.13) | 6.05 (4.21–7.52) | 0.89 | |
| Positive CMV Serostatus before Transplantation | 15 (93.8) | 24 (88.8) | 6 (66.6) | 0.15 | |
| CMV D+/R− serostatus at the time of blood collection | 1 (6.3) | 2 (7.4) | 3 (33.3) | 0.08 | |
| Medication | Tacrolimus (%) | 7 (43.8) | 19 (70.4) | 7 (77.8) | 0.15 |
| Everolimus (%) | 6 (37.5) | 5 (18.5) | 4 (44.4) | 0.27 | |
| Mycophenolatmofetil (%) | 2 (12.5) | 24 (88.9) | 8 (88.9) | <0.001 | |
| Ciclosporin (%) | 0 (0) | 3 (11.1) | 1 (11.1) | 0.38 | |
| Prednisolon (%) | 0 (0) | 1 (3.7) | 7 (77.8) | <0.001 | |
| Sirolimus (%) | 1 (6.3) | 1 (3.7) | 0 (0) | 1 | |
| Valganciclovir | 1 | 0 | 5 | <0.001 | |
| Detected Antigen Approaches (%) | ||||
|---|---|---|---|---|
| Number of Immunosuppressants | 0 | 1 | 2 | 3 |
| 0 | 1 (14.3) | 1 (14.3) | 1 (14.3) | 4 (57,1) |
| 1 | 3 (18.8) | 2 (12.5) | 0 | 11 (68.8) |
| 2 | 6 (22.2) | 4 (14.8) | 6 (22.2) | 11 (40.7) |
| 3 | 7 (77.8) | 1 (11.1) | 0 | 1 (11.1) |
| CMV Peptide Pool Detection | pp65 Detection | Early Antigen Detection | ||||
|---|---|---|---|---|---|---|
| OR (95% CI) | p-Value | OR (95% CI) | p-Value | OR (95% CI) | p-Value | |
| Age | 0.944 (0.889–1.002) | 0.06 | 0.932 (0.881–0.987) | 0.016 | 0.958 (0.911–1.007) | 0.091 |
| Months after Transplantation | 1.007 (0.994–1.019) | 0.29 | 1.001 (0.991–1.011) | 0.862 | 1.00 (0.991–1.010) | 0.923 |
| Renal failure | 4.165 (0.777–22.326) | 0.096 | 2.601 (0.497–13.604) | 0.257 | 2.184 (0.479–9.96) | 0.313 |
| Tacrolimus | 1.314 (0.302–5.713) | 0.716 | 0.569 (0.138–2.344) | 0.435 | 0.512 (0.132–1.993) | 0.334 |
| Prednisolone | 0.065 (0.005–0.84) | 0.036 | 0.048 (0.003–0.699) | 0.026 | 0.144 (0.017–1.196) | 0.073 |
| CMV Reactivation (n = 10) | No CMV Reactivation (n = 42) | p-Value | |
|---|---|---|---|
| Age, median (IQR) | 48.5 (39–65) | 57.5 (48.8–70.0) | 0.13 |
| Gender, male (%) | 5 (50) | 22 (52.4) | 0.89 |
| Months after Transplantation median (IQR) | 37.5 (8.25–95) | 59 (29.5–128.5) | 0.19 |
| 3 immunosuppressive agents, n (%) | 6 (60) | 3 (7.1) | <0.001 |
| D+/R− CMV serostatus | 4 (40) | 2 (4.8) | 0.002 |
| Tacrolimus, n (%) | 6 (60) | 27 (64.3) | 0.8 |
| Mycophenolate mofetile, n (%) | 8 (80) | 26 (61.9) | 0.28 |
| Prednisolone, n (%) | 6 (60) | 3 (7.1) | <0.001 |
| Sandimmun n (%) | 1 (10) | 3 (7.1) | 0.76 |
| Everolimus n (%) | 3 (30) | 11 (26.2) | 0.39 |
| Stimulation Index, median (IQR) | |||
| CMV peptide Pool | 0.5 (0.0–2.88) | 37.3 (1.98–193.88) | <0.001 |
| IE Ag | 0.13 (0.0–1.85) | 9.25 (1.9–42.57) | <0.001 |
| pp65 | 0.61 (0.0–1.85) | 13.5 (0.5–93.22) | 0.004 |
| Mean Spot Count, median (IQR) | |||
| CMV peptide Pool | 0.5 (0.0–27.38) | 105.25 (4.5–267) | 0.002 |
| IE Ag | 0.0 (0.0–0.0) | 12.5 (0.0–113.13) | <0.001 |
| pp65 | 1.75 (0.0–8.60) | 20.88 (1.88–173.63) | 0.012 |
| Mean Spot size × 10−3 mm2, median (IQR) | |||
| CMV peptide Pool | 4.82 (0.0–10.49) | 12.02 (9.03–14.37) | 0.007 |
| IE Ag | 8.27 (0.0–11.55) | 14.42 (10.5–17.8) | 0.002 |
| pp65 | 7.34 (0.0–12.02) | 13.21 (7.50–16.53) | 0.025 |
Disclaimer/Publisher’s Note: The statements, opinions and data contained in all publications are solely those of the individual author(s) and contributor(s) and not of MDPI and/or the editor(s). MDPI and/or the editor(s) disclaim responsibility for any injury to people or property resulting from any ideas, methods, instructions or products referred to in the content. |
© 2024 by the authors. Licensee MDPI, Basel, Switzerland. This article is an open access article distributed under the terms and conditions of the Creative Commons Attribution (CC BY) license (https://creativecommons.org/licenses/by/4.0/).
Share and Cite
Traska, A.-K.; Nowacki, T.M.; Vollenberg, R.; Rennebaum, F.; Meier, J.A.; Schomacher, T.; Reinartz Groba, S.N.; Fischer, J.; Trebicka, J.; Tepasse, P.-R. Immunomonitoring via ELISPOT Assay Reveals Attenuated T-Cell Immunity to CMV in Immunocompromised Liver-Transplant Patients. Cells 2024, 13, 741. https://doi.org/10.3390/cells13090741
Traska A-K, Nowacki TM, Vollenberg R, Rennebaum F, Meier JA, Schomacher T, Reinartz Groba SN, Fischer J, Trebicka J, Tepasse P-R. Immunomonitoring via ELISPOT Assay Reveals Attenuated T-Cell Immunity to CMV in Immunocompromised Liver-Transplant Patients. Cells. 2024; 13(9):741. https://doi.org/10.3390/cells13090741
Chicago/Turabian StyleTraska, Ann-Kristin, Tobias Max Nowacki, Richard Vollenberg, Florian Rennebaum, Jörn Arne Meier, Tina Schomacher, Sara Noemi Reinartz Groba, Julia Fischer, Jonel Trebicka, and Phil-Robin Tepasse. 2024. "Immunomonitoring via ELISPOT Assay Reveals Attenuated T-Cell Immunity to CMV in Immunocompromised Liver-Transplant Patients" Cells 13, no. 9: 741. https://doi.org/10.3390/cells13090741





